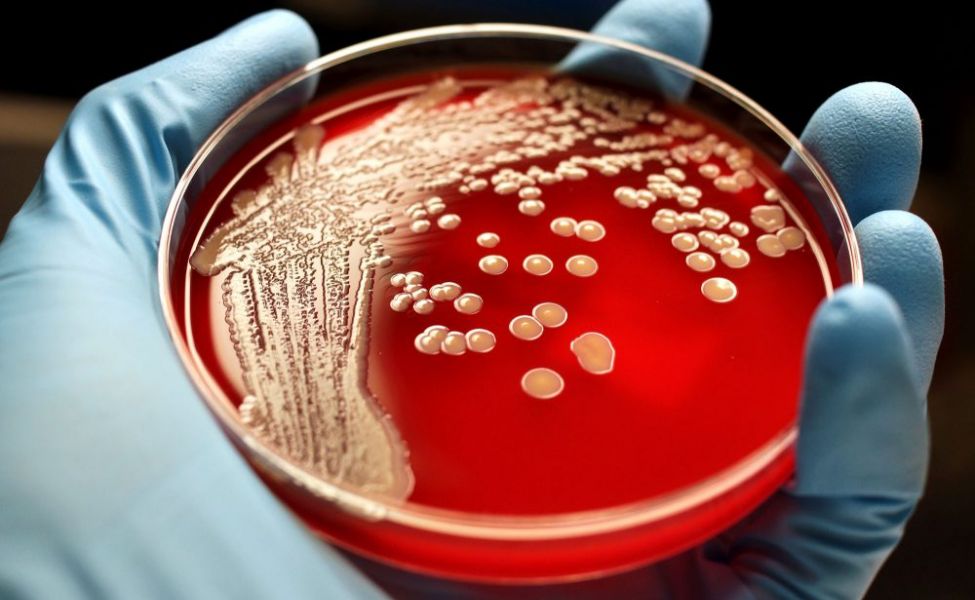

Состояние пациентов стабильное
В департаменте санитарно-эпидемиологического контроля региона сообщили, что заболевшие указали на возможный источник зараженного мяса, сообщается на Telegram-канале Межведомственной комиссии по нераспространению коронавируса в РК.
"По словам больных, мясо привезли из Жамбылской области. Следственно-проверочной работой по вопросам, у кого именно и где было приобретено мясо, занимаются компетентные органы", - говорится в сообщении ДСЭК региона.
Между тем в ДСЭК области заявили, что "аудиозапись касательно сибирской язвы, распространяемая в последние дни через мессенджер Whats App, не соответствует действительности", пояснив, что мясо больных животных не было закуплено в Туркестанской области.
Пациенты, один из которых получает лечение в Акмолинской области, другой в Туркестанской, скоро будут выписаны из стационаров.
Фото: nokkvd.ru.